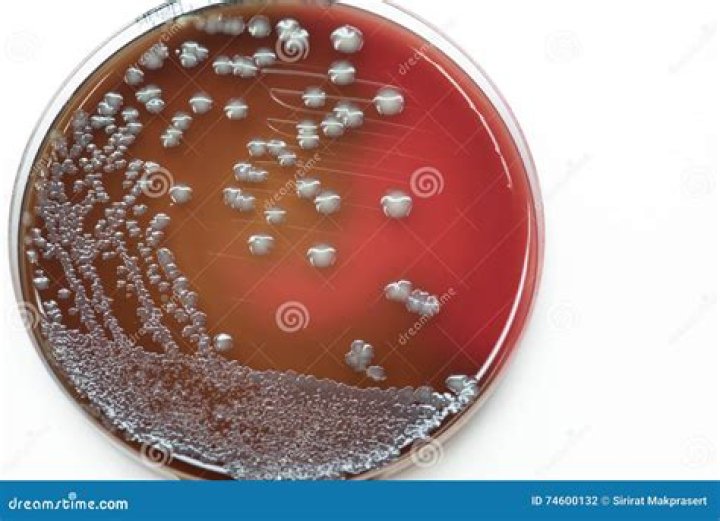

Eurasian Economic Union
.
Also question is, is Russia in the EU Union?
Russian–European Union relations are the international relations between the European Union (EU) and its largest bordering state, Russia, to the east. Furthermore, four European Union-Russia Common Spaces are agreed as a framework for establishing better relations.
Secondly, is Belarus allies with Russia? Belarus–Russia relations. Russia is the largest and most important partner for Belarus both in the political and economic fields. The Treaty on Equal Rights of Citizens between Belarus and Russia was signed in December 1998, covering employment, and access to medical care and education.
Correspondingly, are there unions in Russia?
In Russia there are two types of trade unions: those that survived from the Soviet era and the newly established ones that have appeared independently. RIR discovers what trade unions do in Russia and some difficulties they face. In the USSR, membership of a trade union was compulsory.
Is Russia a democracy?
The 1993 constitution declares Russia a democratic, federative, law-based state with a republican form of government. State power is divided among the legislative, executive, and judicial branches. Diversity of ideologies and religions is sanctioned, and a state or compulsory ideology may not be adopted.
Related Question Answers
Why is Switzerland not part of EU?
Switzerland signed a free-trade agreement with the then European Economic Community in 1972, which entered into force in 1973. However, after a Swiss referendum held on 6 December 1992 rejected EEA membership by 50.3% to 49.7%, the Swiss government decided to suspend negotiations for EU membership until further notice.Do you need a visa to go to Russia?
Entry Visas To enter Russia for any purpose, a U.S. citizen must possess a valid U.S. passport and a bona fide visa issued by a Russian Embassy or Consulate. It is impossible to obtain an entry visa upon arrival, so travelers must apply for their visas well in advance.Can Russia join NATO?
Formal contacts and cooperation between Russia and NATO began in 1991, within the framework of the North Atlantic Cooperation Council (later renamed Euro-Atlantic Partnership Council), and were further deepened as Russia joined the Partnership for Peace program on 22 June 1994.Why does Britain want to leave the EU?
Age of voters It is argued that older voters were more likely to vote 'leave' due to having experienced life in the UK prior to 1973, when the UK joined the European Economic Community which later became the EU, and this memory as well as any potential nostalgia may have influenced their decision.Why is Norway not in the EU?
Norway has high GNP per capita, and would have to pay a high membership fee. The country has a limited amount of agriculture, and few underdeveloped areas, which means that Norway would receive little economic support from the EU. The total EEA EFTA commitment amounts to 2.4% of the overall EU programme budget.Is Monaco in EU?
Monaco is a part of the EU customs territory through an agreement with France, and is administered as part of France. San Marino and Andorra are in a customs union with the bloc. Liechtenstein, as a member of the EEA, is within the EU internal market and applies certain EU laws.Is Serbia in EU?
Serbia officially applied for European Union membership on 22 December 2009. Accession negotiations are currently ongoing. It is one of five current EU candidate countries, together with Albania, Montenegro, North Macedonia, and Turkey.Is Romania in European Union?
Romania joined the European Union on 1 January 2007. Also .eu, shared with other European Union member states.What country did Russia just take over?
Ukrainian military forces The Crimean Peninsula was annexed by the Russian Federation in February–March 2014 and since then has been administered as two Russian federal subjects—the Republic of Crimea and the federal city of Sevastopol.Why is Belarus separate from Russia?
During the negotiations of the Treaty of Brest-Litovsk, Belarus first declared independence under German occupation on 25 March 1918, forming the Belarusian People's Republic. Immediately afterwards, the Polish–Soviet War ignited, and the territory of Belarus was divided between Poland and Soviet Russia.Is Belarus a third world country?
The United States, Canada, Japan, South Korea, Western European nations and their allies represented the First World, while the Soviet Union, China, Cuba, and their allies represented the Second World. Some countries in the Communist Bloc, such as Cuba, were often regarded as "third world".Is Belarus dangerous?
Belarus is generally a safe place for travelers. Violent crimes against travelers are rare, however you should always exercise common sense. If you find yourself in a dangerous situation, don't be a hero – hand over whatever it is the perpetrator is asking for, or try to walk away and find a safe place.Is Ukraine part of Russia?
Ukraine is currently in a territorial dispute with Russia over the Crimean Peninsula, which Russia annexed in 2014. Including Crimea, Ukraine has an area of 603,628 km2 (233,062 sq mi), making it both the largest country entirely within Europe and the 46th largest country in the world.Is Belarus a communist?
The Communist Party of Belarus (CPB), part of the Communist Party of the Soviet Union (CPSU), claimed to rule the Belarusian SSR in the name of the proletariat for the entire duration of the republic's existence.How wealthy is Belarus?
The economy of Belarus is world's 72nd largest economy by GDP based on purchasing power parity (PPP), which in 2019 stood at $195 billion, or $20,900 per capita.Is Russia still in Crimea?
Russia annexed Crimea in 2014 following a referendum, and administers it as two federal subjects of Russia, and claimed it to be 'fully integrated' in July 2015. Ukraine and the majority of international governments continue to regard Crimea as an integral part of Ukraine.Did Minsk used to be in Russia?
In 1242, Minsk became part of the Grand Duchy of Lithuania. From 1919 to 1991, after the Russian Revolution, Minsk was the capital of the Byelorussian Soviet Socialist Republic, in the Soviet Union. In June 2019, Minsk hosted the 2019 European Games.Is Turkey a democracy?
The politics of Turkey takes place in a framework of a presidential republic, whereby the President of Turkey is the head of government and the head of state who holds executive powers to issue executive decrees, appoint judges and heads of state institutions.What is Russia's government type?
Semi-presidential system Federal republic Constitutional republic